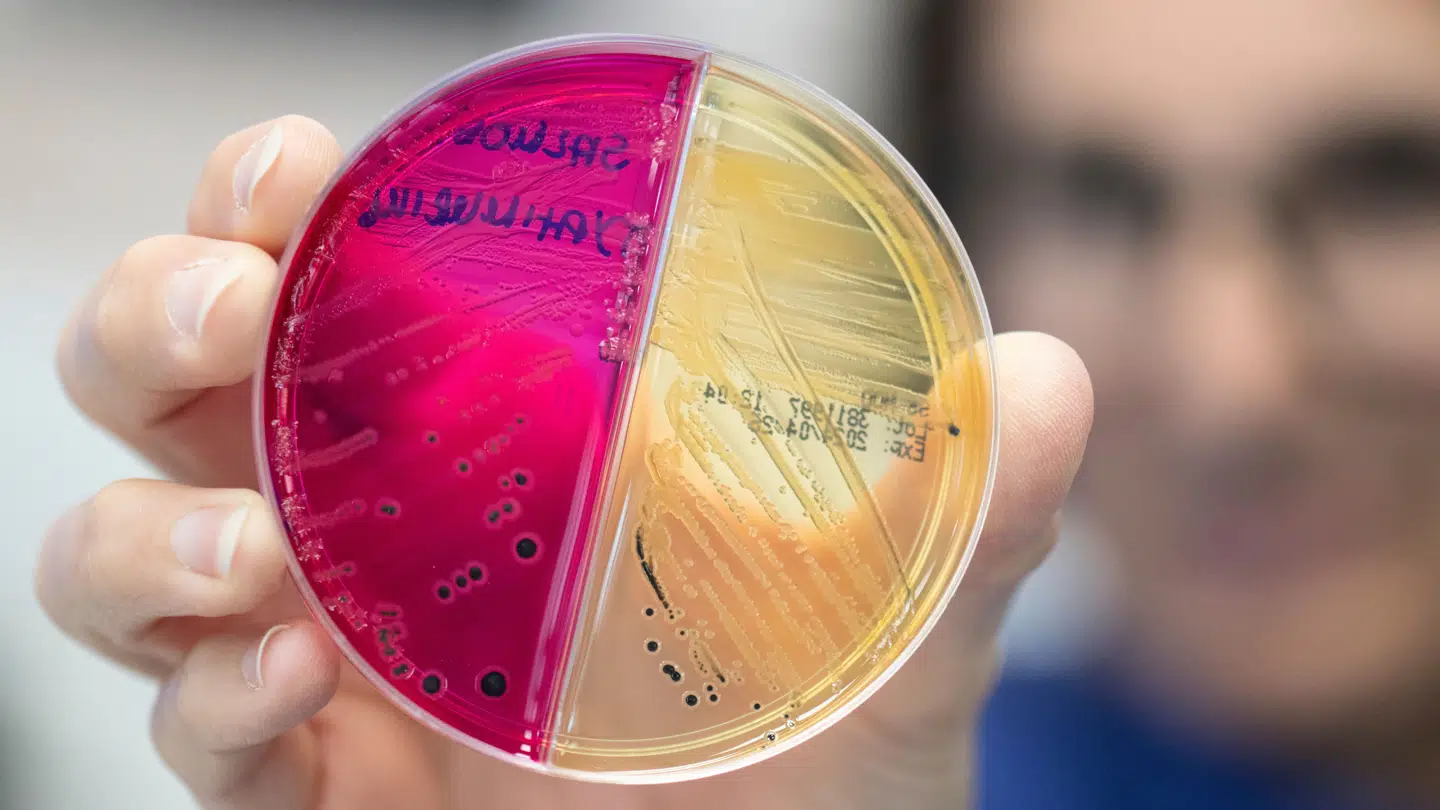
Bakterieprøver og oplysninger fra patienternes betalingskort skal i nyt projekt hjælpe SSI til at finde kontaminerede fødevarer.

Opkast. Diarré. Mavesmerter. De fleste har prøvet en madforgiftning. Hver gang et udbrud af for eksempel salmonella eller listeria rammer, er det et »kapløb med tiden.«
Nu skal et forskningsprojekt gøre Statens Serum Institut hurtigere og bedre til at stoppe et smitteudbrud. Men det kræver, at vi giver adgang til vores bankkonto og kvitteringer.
Hvert år bliver omkring 100.000 danskere syge af fordærvet mad. Tusindvis bliver så dårlige, at de må til lægen eller på hospitalet. 90 af dem dør.
»For et udbrud fortsætter ofte, indtil man finder kilden,« siger afdelingslæge på SSI, Frederik Trier Møller.
For at forstå hvordan dét hænger sammen, spoler vi tiden tilbage til sidste forår, hvor hakket oksekød inficeret med salmonella lagde mange danskere ned.
For de fleste kostede det en sygedag eller to, men 133 blev så dårlige, at de fik taget blod- eller afføringsprøver, der viste samme type salmonella, og SSI gik sammen med Fødevarestyrelsen på jagt efter kilden.
Hidtil har forskerne kunnet finde fordærvede fødevarer ved at lave rutinetjek i virksomheder eller ved at spørge de smittede, hvilke fødevarer de har købt – og hvor.
»Det kan være svært nok at finde smittekilden. Men hvis det er en enkelt ingrediens i en pølse, der er årsag til et udbrud, kan det være næsten umuligt,« siger han.

Nogle gange spænder tiden ben, både for forbrugers hukommelse, og dermed også for forskernes mulighed for at finde en smittekilde.
»Nogle udbrud er hurtigt afklaret. Er det maden i en kantine eller restaurant, eller er det én bestemt fødevare, der er årsag til smitten, kan det være løst på et par dage.«
Men mens der går få dage, fra man spiser mad inficeret med salmonella- og campylobactorbakterier, til man bliver syg, kan en listeria-infektion skyldes fødevarer, der er købt uger eller måneder tilbage.
»Listeria-udbrud er virkelig svære. Det er ikke så mange, der bliver syge, men dem, der gør, bliver meget syge og ofte er det dem, der er svækket i forvejen.«
Nu giver forskningsprojektet 'Foodsafe' forsøgsvis SSI mulighed for at hurtigere at finde en smittekilde.
»Vi udvikler et redskab, der gør os i stand til med samtykke fra borgerne, at få direkte indsigt i, hvad de har købt og hvornår, uden at det er besværligt for borgerne,« siger Frederik Trier Møller.
Danskere, der hos lægen har fået bekræftet, at de har en fødevarebåren infektion, kan forvente at få brev fra SSI.
»I e-Boks spørger vi, om de vil give digitalt samtykke til, at SSI må få adgang til informationer om deres indkøb.«
Med samtykket kan forskerne trække data fra de transaktioner, som forbrugerne i en afgrænset periode har foretaget med deres betalingskort.
»Kan vi se, at en enkelt virksomhed går igen hos flere syge, kan vi sammen med Fødevarestyrelsen bede virksomheden om kvitteringer fra de bestemte kunder. Måske kan vi så se et sammenfald i de fødevarer, der er købt,« siger Frederik Trier Møller og fortsætter:
»Eller måske får vi øje på hygiejneproblemer, hvis mange patienter har været på den samme restaurant eller kantine.«
Frederik Trier Møller understreger, at hverken supermarkeder eller restauranter vil få at vide, hvem kunderne er.
Men det stopper ikke der.
»Et fremtidsperspektiv er, at man måske kan lave en service, hvor man som kunde kan få en advarsel, hvis man har købt produkter, som er blevet tilbagekaldt.«
Men det kræver, at I overvåger forbrugerne og deres køb. Er det ikke problematisk?
»Det er klart, at man kun kan advare folk, hvis deres køb bliver registreret. Før folk melder sig til sådan en service, vil det selvfølgelig kræve, at den er grundigt forberedt, sikker, og at man bevarer privatlivet.«
Lige nu er det forsøgsprojektet, det gælder. Men også her er privatlivet i fokus, lover han:
»Det er frivilligt, om man vil videregive sine oplysninger. Desuden begrænser vi de data, vi indsamler til få måneder, og vi ser kun transaktioner fra supermarkeder, restauranter og kantiner, men kigger for eksempel ikke på transaktioner fra banken.«
Frederik Trier Møller håber, danskerne vil være med:
»Kan vi reducere de fødevarebårne udbrud med 10 procent om året, så er det 10.000 mennesker, der ikke bliver syge eller indlagt, og det er 10, der ikke dør. Det betaler sig for samfundet.«

